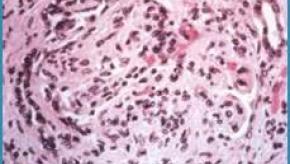
glomerulonephritis.GN_.lupus_.jpg

All News
Axial Involvement in Psoriatic Arthritis
Analysis of a Greek Psoriatic Arthritis (PsA) cohort shows that nearly one quarter of patients have axial involvement, and among them, ∼30% have isolated spinal axPsA and nr-axSpA, respectively.
Mizoribine Effective in Lupus Nephritis
A randomized clinical trial has shown that oral mizoribine, a common immunosuppressant in Japan, was noninferior to intravenous cyclophosphamide (CTX) as induction therapy in patients with active lupus nephritis.
Read ArticleWorld Changers (3.14.2025)
Dr Jack Cush and his podcast friends are out to change the world. Here is his weekly review of the news and journal reports from the past week on RheumNow.
Read ArticleChanneling Bias and Cancer Risk with Biologic or Targeted Synthetic DMARDs
A retrospective US administrative claims cohort study of RA patients on tumor necrosis factor inhibitors (TNFis), non-TNFi biologics, or Janus kinase inhibitors (JAKis) found a statistically significantly higher risk of incident cancer in patients receiving rituximab, abatacept, or JAKis (compared with TNFis).
Read ArticleEarlier ACL reconstruction and a lower risk of knee osteoarthritis
A preclinical study by HSS investigators found that earlier anterior cruciate ligament (ACL) reconstruction led to lower immune cell activity, less inflammation and fewer joint changes associated with knee osteoarthritis compared to delayed surgery.
Read Article









Links: